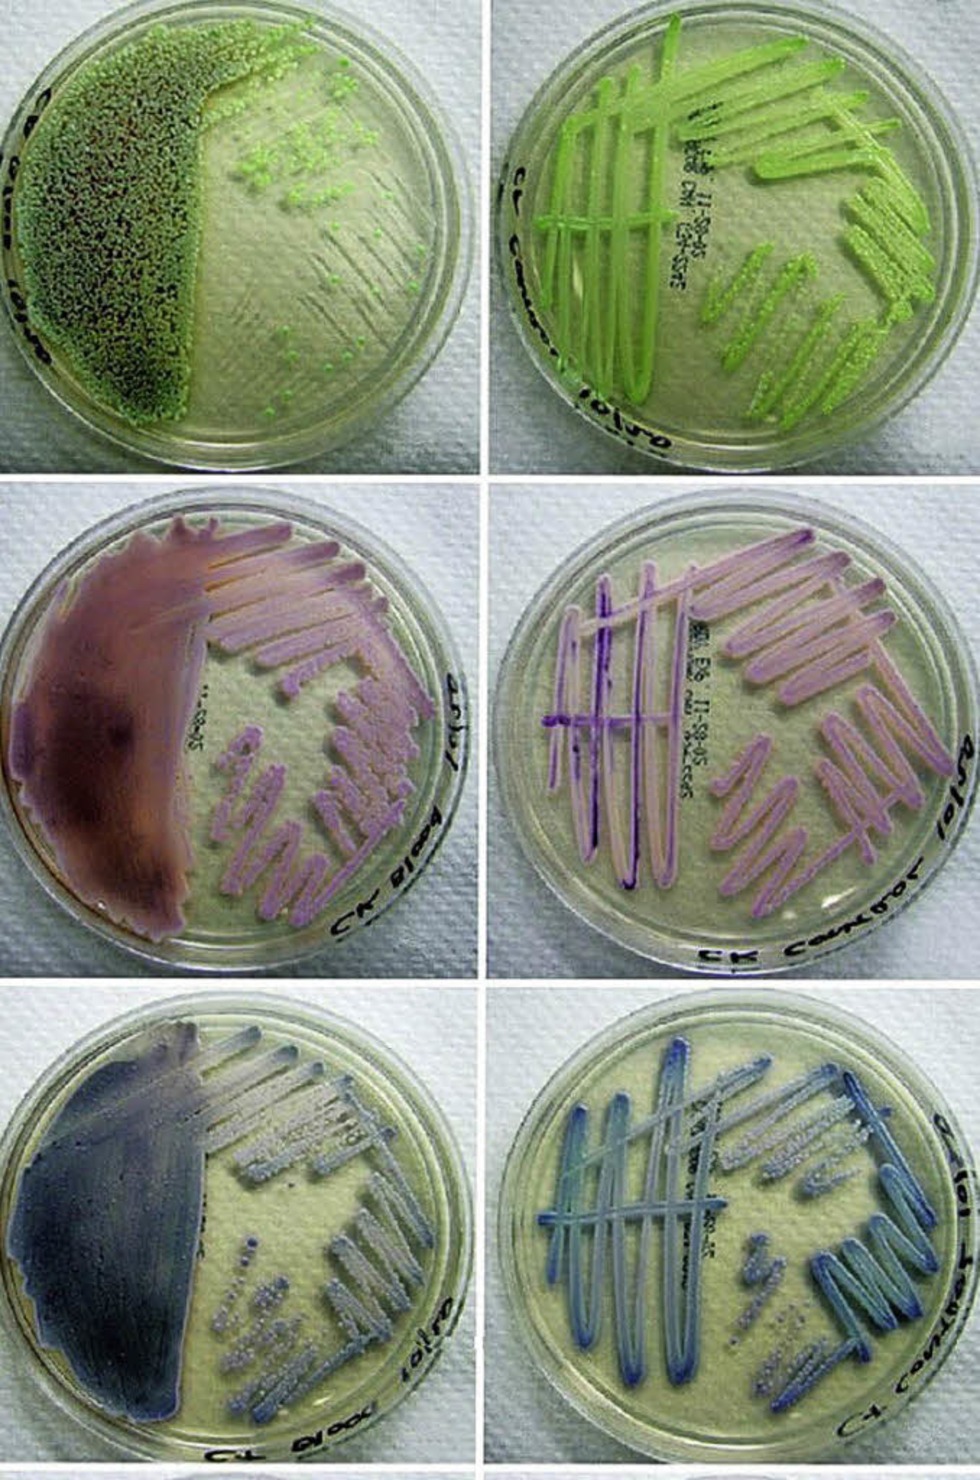

C tropicalis
Песня бабабой
Точка на карте страны
Как пожарить стейк кижуча
Tomorrowland 2025 tracklist
Ты такой милашка 10 глава
Тур поездка в санкт петербург
Красноармейская 93 г
Ул ванеева 45
Конденсатор к5
Material design это
Что значит не кашляйте
14 про на 128 гб
Олигурия отеки
C tropicalis 29 фотографий